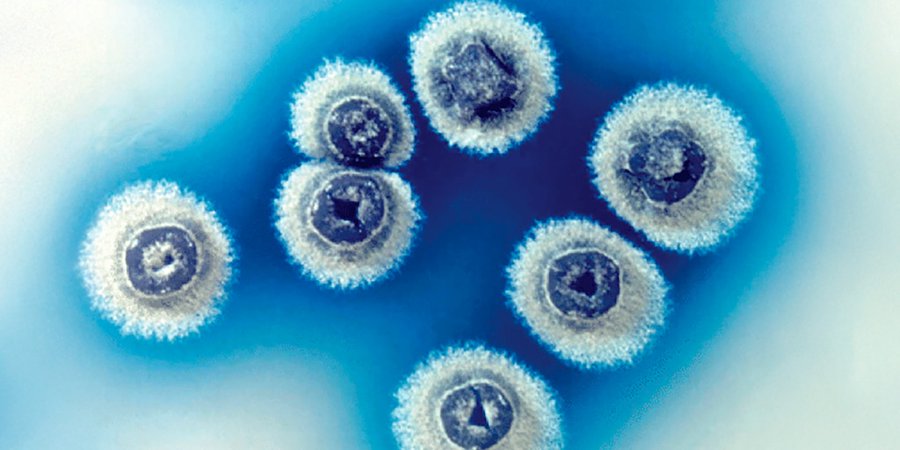

Científicos del Reino Unido y Australia detectaron la molécula pre-metilenomicina C lactona en una bacteria del suelo. Cómo la encontraron y cuáles son los desafíos a superar para que puedan ser aplicadas en humanos y animales
Desde 1950, se estudia a la bacteria del suelo Streptomyces coelicolor. Su modo de vida incluye producir antibióticos naturales que la ayudan a defenderse en el ambiente.
Un grupo de científicos del Reino Unido y Australia quiso saber si en ese proceso había aún secretos por descubrir.

Así, dieron con una molécula nunca explorada, la pre-metilenomicina C lactona, y descubrieron que puede servir para eliminar bacterias resistentes a los antibióticos actuales, incluyendo aquellas que causan infecciones hospitalarias difíciles de tratar, es decir, a las superbacterias.
El hallazgo fue publicado en la revista Journal of the American Chemical Society. Aunque los resultados en laboratorio son prometedores, todavía se necesita mucha investigación para saber si este antibiótico es seguro y efectivo en los seres vivos.
Bacterias resistentes y nuevas estrategias

En hospitales, bacterias como Staphylococcus aureus (MRSA) y enterococos resistentes a la vancomicina causan infecciones difíciles, que en muchos casos no responden a los antibióticos más usados.
La Organización Mundial de la Salud (OMS) ya advirtió sobre la falta de nuevos agentes antimicrobianos. El avance de la resistencia complica el tratamiento de enfermedades graves.
Gran parte de los antibióticos que se utilizan fueron descubiertos hace muchos años. Hoy casi no se encuentran antibióticos nuevos al usar estrategias tradicionales.

Por eso, el equipo de la Universidad de Warwick, del Reino Unido y la Universidad Monash de Australia decidió cambiar el enfoque. Los líderes del grupo fueron Greg Challis y Lona Alkhalaf.
El camino elegido consistió en fijarse en los pasos intermedios del proceso natural de la bacteria, no solo en el producto final, para detectar posibles sustancias activas. Así, querían ver si esas etapas podrían esconder antibióticos más poderosos.
El hallazgo en detalle y sus consecuencias

La metilenomicina A es un antibiótico natural producido por la bacteria del suelo Streptomyces coelicolor. Aunque se conoce desde hace décadas, su potencia es baja y no se utiliza en medicina.
Para avanzar en el estudio, los científicos modificaron genéticamente a la bacteria Streptomyces coelicolor y bloquearon su capacidad de fabricar metilenomicina A.
Esta intervención permitió que se acumularan compuestos intermedios dentro de la bacteria y así pudieron aislarlos y analizarlos.
Uno de esos compuestos fue la “pre-metilenomicina C lactona”, que se destacó porque su eficacia superó ampliamente la de los antibióticos conocidos.
Las pruebas demostraron que puede eliminar bacterias Gram-positivas como Staphylococcus aureus y Enterococcus faecium. Ambas bacterias causan infecciones graves en hospitales de todo el mundo.

Un dato clave es que durante los ensayos no apareció resistencia bacteriana contra el nuevo antibiótico.
No se detectó ninguna aparición de resistencia contra pre-metilenomicina C lactona en Enterococcus, mientras que la resistencia a la vancomicina sí apareció, informaron los investigadores.
Esto fue considerado inusual y alentador. Para los investigadores representa una innovación en la búsqueda de nuevos antibióticos.
“Streptomyces coelicolor producía una joya que habíamos pasado por alto”, afirmó Lona Alkhalaf.

El grupo también halló una forma de sintetizar la pre-metilenomicina C lactona en el laboratorio. Así se podrán fabricar variantes del compuesto y probarlas en nuevas investigaciones.
“Esta ruta sintética permitirá crear análogos diversos que ayuden a analizar su mecanismo de acción“, explicó David Lupton, investigador en química sostenible en la Universidad Monash. Esto amplía las oportunidades para crear mejores antibióticos en el futuro.
Desafíos y el camino por recorrer

A partir de los resultados, los científicos consideraron que se deberían estudiar más los compuestos intermedios en la producción de antibióticos naturales. En estos pasos podrían estar las “sorpresas” que faltan aún por descubrir.
Hasta el momento, la pre-metilenomicina C lactona solo fue evaluada en cultivos de laboratorio. Todavía no existen datos sobre su eficacia y seguridad en animales o personas.
El siguiente reto será realizar estudios preclínicos. Si el compuesto se comporta igual de bien en esas fases, podría llegar a ser una solución para infecciones que hoy resultan imposibles de tratar.
En diálogo con Infobae, el médico infectólogo Pablo Scapellatto, de la Sociedad Argentina de Infectología, comentó: “La aparición de nuevas moléculas para tratar gérmenes siempre es una buena noticia. Si tienen un nuevo blanco o mecanismo de acción como el que se muestra en el nuevo trabajo es mucho mejor porque todo lo que va apareciendo es un reciclado de viejas moléculas y eso hace más probable la emergencia de resistencias”.